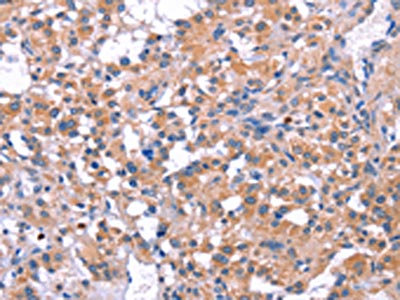

ELP2 Antibody
-
中文名稱:ELP2兔多克隆抗體
-
貨號:CSB-PA944356
-
規(guī)格:¥1100
-
圖片:
-
The image on the left is immunohistochemistry of paraffin-embedded Human liver cancer tissue using CSB-PA944356(ELP2 Antibody) at dilution 1/40, on the right is treated with fusion protein. (Original magnification: ×200)
-
The image on the left is immunohistochemistry of paraffin-embedded Human thyroid cancer tissue using CSB-PA944356(ELP2 Antibody) at dilution 1/40, on the right is treated with fusion protein. (Original magnification: ×200)
-
-
其他:
產(chǎn)品詳情
-
Uniprot No.:
-
基因名:ELP2
-
別名:AU023723 antibody; Elongation protein 2 homolog (S. cerevisiae) antibody; Elongator acetyltransferase complex subunit 2 antibody; Elongator complex protein 2 antibody; elongator protein 2 antibody; ELP2 antibody; ELP2_HUMAN antibody; Epl2 antibody; FLJ10879 antibody; SHINC 2 antibody; SHINC-2 antibody; SHINC2 antibody; signal transducer and activator of transcription 3 interacting protein 1 antibody; signal transducer and activator of transcription interacting protein 1 antibody; STAT3 interacting protein 1 antibody; Stat3 interacting protein antibody; STAT3-interacting protein 1 antibody; STATIP 1 antibody; STATIP1 antibody; STATIP1 protein antibody; StIP antibody; StIP1 antibody
-
宿主:Rabbit
-
反應(yīng)種屬:Human,Rat
-
免疫原:Fusion protein of Human ELP2
-
免疫原種屬:Homo sapiens (Human)
-
標(biāo)記方式:Non-conjugated
-
抗體亞型:IgG
-
純化方式:Antigen affinity purification
-
濃度:It differs from different batches. Please contact us to confirm it.
-
保存緩沖液:-20°C, pH7.4 PBS, 0.05% NaN3, 40% Glycerol
-
產(chǎn)品提供形式:Liquid
-
應(yīng)用范圍:ELISA,IHC
-
推薦稀釋比:
Application Recommended Dilution ELISA 1:2000-1:5000 IHC 1:50-1:200 -
Protocols:
-
儲(chǔ)存條件:Upon receipt, store at -20°C or -80°C. Avoid repeated freeze.
-
貨期:Basically, we can dispatch the products out in 1-3 working days after receiving your orders. Delivery time maybe differs from different purchasing way or location, please kindly consult your local distributors for specific delivery time.
-
用途:For Research Use Only. Not for use in diagnostic or therapeutic procedures.
相關(guān)產(chǎn)品
靶點(diǎn)詳情
-
功能:Component of the RNA polymerase II elongator complex, a multiprotein complex associated with the RNA polymerase II (Pol II) holoenzyme, and which is involved in transcriptional elongation. The elongator complex catalyzes formation of carboxymethyluridine in the wobble base at position 34 in tRNAs.
-
基因功能參考文獻(xiàn):
- ELP2 mutation is implicated in severe intellectual disability, spastic diplegia, and self-injurious behavior described in two brothers. PMID: 25847581
- Studied the possible relationship between STATIP1, STAT3 and CML resistance. PMID: 25417721
- Elp2 and STAT-3 mediate, at least in part, the stimulation of Hsp70 expression by 4PBA. PMID: 22069317
-
相關(guān)疾病:Mental retardation, autosomal recessive 58 (MRT58)
-
亞細(xì)胞定位:Cytoplasm. Nucleus.
-
蛋白家族:WD repeat ELP2 family
-
數(shù)據(jù)庫鏈接:
Most popular with customers
-
-
Phospho-YAP1 (S127) Recombinant Monoclonal Antibody
Applications: ELISA, WB, IHC
Species Reactivity: Human
-
-
-
-
-
-